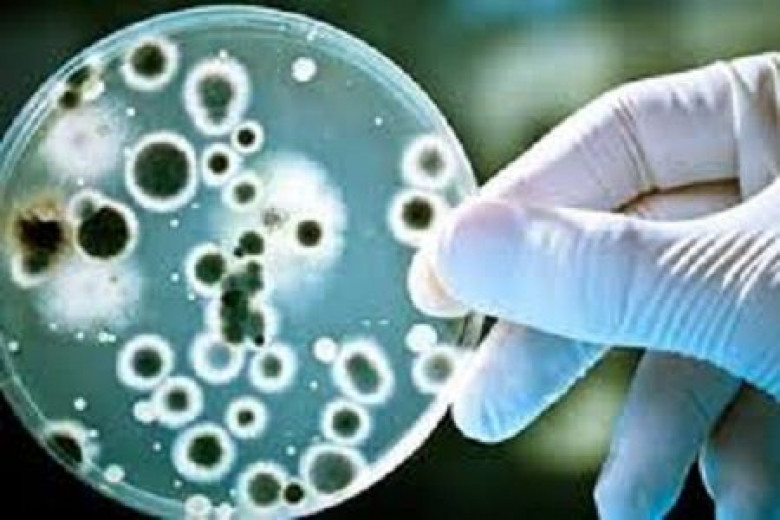

«Հրապարակ». Բրուցելոզի վարակը տարածվում է
Հասարակություն
«Կոտայքի մարզի Սոլակ գյուղում անասունների շրջանում բրուցելյոզի վարակը փոխանցվել է մարդկանց՝ վարակվել է նաև գյուղացիներից մեկը, ով տեղափոխվել է Նորքի ինֆեկցիոն հիվանդանոց և այնտեղ դեռևս մեկ շաթաթ էլ կմնա: Մեզ հետ զրույցում այս մասին ասաց «Հիվանդությունների վերահսկման և կանխարգելման ազգային կենտրոն» ՊՈԱԿ-ի հատուկ վտանգավոր վարակների բաժնի պետ Լիանա Թորոսյանը և հավելեց, որ հիվանդանոց տեղափոխված անձի ընտանիքի երկու անդամների մոտ ևս հայտնաբերվել է բրուցելյոզ, կորոշվի՝ նրանց պե՞տք է հոսպիտալացնել, թե՞ բուժումը կարող են կազմակերպել ամբուլատոր եղանակով:
Լիանա Թորոսյանն ասաց, որ համատեղ աշխատանքներ են կատարվում, երկու խումբ աշխատում է տեղում, պատրաստ են բոլոր թիրախային անձանցից, գանգատներ ունեցողներից անալիզ վերցնել, որպեսզի տեսնեն՝ նրանց մոտ առկա՞ է բրուցելյոզ, թե՞ ոչ: Մինչ Սոլակ համայնքում սպանդի են ենթարկվում հիվանդ անասունները, հերթական զանգը եղավ Կոտայքի մարզի Բջնի համայնքից, որտեղ ևս կան բրուցելյոզով հիվանդ անասուններ: Ինֆորմացիան ճշտելու համար զանգահարեցինք համայնքի ղեկավար Ա. Մաթևոսյանին, ով մեզ հայտնեց, որ, ցավոք, դեպքեր գրանցվել են: «Մի փոքր ուշ զանգահարեք, ստույգ տվյալներ կասեմ», ասաց նա: Սակայն ավելի ուշ մեր հեռախոսազանգերը մնացին անպատասխան: Կոտայքի մարզպետարանի գյուղատնտեսություն և բնապահպանության վարչությունում հաստատեցին, որ Բջնիում նույնպես բրուցելյոզով հիվանդ անասուններ կան»,–գրում է թերթը։
Մանրամասները՝ թերթի այսօրվա համարում։